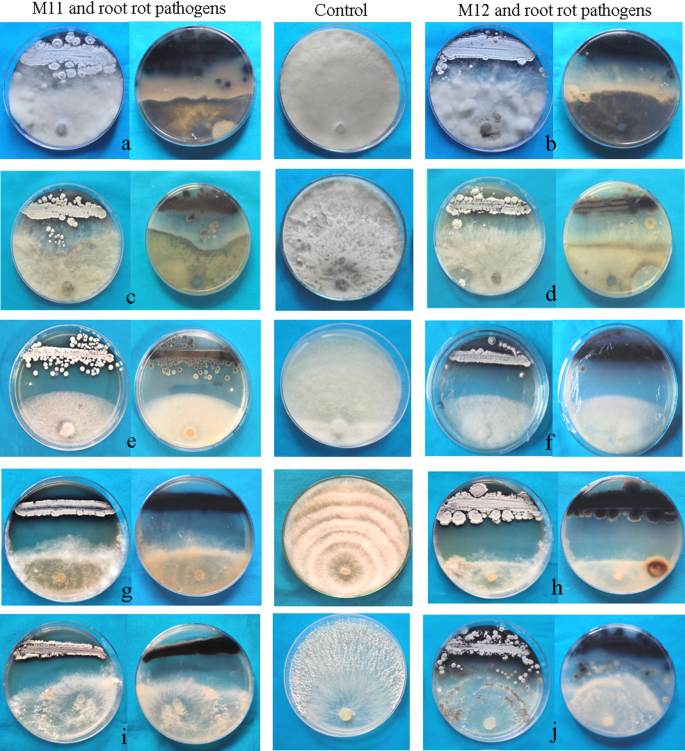

- Research
- Open access
- Published:
Actinoalloteichus cyanogriseus: a broad spectrum bio-agent against mulberry root rot pathogens
Egyptian Journal of Biological Pest Control volume 32, Article number: 33 (2022)
Abstract
Background
In India, severe yield and economic losses in sericulture were reported due to mulberry root rot disease. Since the disease was caused by complex soil-borne pathogens with wide host range, an attempt was made to develop actinobacteria based biological management strategy to mitigate it.
Results
As a result of continuous screening for anti-fungal actinobacteria, 2 novel and potent isolates (M11 and M12) belong to the rare genus, Actinoalloteichus were obtained from mulberry rhizosphere. Both isolates were gram positive, grayish, aerobic and produced good amount of melanin pigment during sporulation. They exhibited excellent anti-fungal activity against mulberry root rot pathogens viz., Macrophomina phaseolina, Lasiodiplodia theobromae, Fusarium solani, Sclerotium rolfsii and Rhizoctonia solani. In addition, these melanogenic isolates grew in wide temperature and pH ranges. Their multi-stress tolerance ability/polyextremophilic nature was exposed when amending regular growth medium with excess concentration of salt and alkali. In addition, the potent isolates also showed tolerance to carbendazim (up to 1000 ppm) and UVB irradiation (up to 180 min at 10 cm distance).
Conclusion
The present study focused on the identification and characterization of melanogenic actinobacteria, further made it potential candidate that could be incorporated in eco-friendly, integrated disease management strategies against complex mulberry root rot pathogens.
Background
Mulberry is a perennial, evergreen, fast growing tree belonging to Moraceae family. Out of known 150 species of Morus, variants derived from species like M. indica, M. alba, M. lavigata and M. multicaulis are high in demand for silkworm areas across the world (Ramesh et al. 2014). Outbreak of mulberry root rot disease is more frequent, because of intense cultivation, loss of plant vigor and increased susceptibility to soil-borne pathogens thereby limiting leaves yield and silk production. The disease was caused by fungal complex with a wide host range, and the severity was influenced by micro and macro climatic factors (Chowdary and Reddy 2004).
Root rot disease of mulberry was recorded plant mortality of 30%, leaf yield loss of 31.5% and reduction in cocoon production by 756 kg/ha garden (Chowdary and Govindaiah 2009). Mukunda et al. (2021), also estimated leaf yield loss of 37.82% due to Macrophomina. This economically important disease of mulberry has been managed by various integrated strategies (Choudhari et al. 2012). However, rising fungicide resistance in phytopathogens, residual toxicity on silkworms and imbalances in the microbial community, soil contamination, health hazards necessitate the implementation of alternate management strategies without chemicals (Jimenez-Diaz et al. 2015). Nowadays, biological methods are given additional importance to overcome the adverse situations in a constructive way.
“Actinobacteria” or “actinomycetes” or “ray fungi” are ubiquitous, hetrotrophic filamentous sub-group of bacteria found abundant in soil and marine environments. Mostly, they are aerobic and responsible for the distinctive scent “petrichor” from the soil during rain after dry spell. They sporulate in chains, produce both aerial and substrate mycelia, with or without diffusible pigments in agar (Gottlieb 1973). These ecologically significant groups are acting as a source of most of the known antibiotics, secondary metabolites, bio-enzymes and other industrially important compounds (Khanna et al. 2011) out of which 60% used as insecticides, fungicides, herbicides and anti-viral in agriculture (Abdallah et al. 2013). While applying these bio-inocula, resistance against the pathogens could be induced in plants by priming defense related pathways (Conn et al. 2008) and in addition it is well known for its irreplaceable role in soil ecology. Mono or poly extremophilic characteristics of actinobacteria like drought tolerant, halo tolerant and low moisture conditions made them advantageous over present bio-agents (Shrivastava and Kumar 2015).
In the present study, an attempt was made to isolate, characterize and ascertain the antagonistic role of melanogenic actinobacterial strains from mulberry rhizosphere against root rot pathogens.
Methods
Isolation and identification of mulberry root rot pathogens
Diseased mulberry roots were rinsed with water, fragmented followed by surface sterilization with sodium hypochlorite (1%), ethanol (70%) and thrice with sterile water. Aseptically air dried root bits were inoculated on Potato Dextrose Agar (PDA) and incubated at 28 ± 2 °C for 7 days (Pappachan et al. 2020). Pure cultures were obtained by hyphal tip method and identified based on colony characteristics, spore/sclerotia morphology (Mihail 1992). Detached root cortex technique (Yoshida et al. 2001) with slight modifications was adopted to prove Koch’s postulates. For molecular confirmation, genomic DNA was extracted by CTAB method followed by amplification of internal transcribed spacer (ITS) region using primers ITS1 and ITS4 (He 2000).
Isolation of actinobacteria
Soil samples collected from the healthy mulberry rhizosphere were utilized to isolate actinobacteria. The composite soil was subjected to heat treatment for 4 h at 45 °C (Saadoun et al. 1999). This was followed by standard serial dilution spread plate technique on starch casein agar (SCA) and incubated at 32 ± 5 °C for 7–10 days. Powdery, bright colonies appeared from 3rd day onwards and colonies producing black/dark pigments were picked for further study. Pure cultures were maintained on SCA slants and in 30% glycerol stock (Oskay et al. 2004).
Screening of melanogenic actinobacteria against root rot pathogens
Melanogenic isolates were tested against the pathogens in-vitro for their antagonistic activity by dual culture technique. The actinobacterial isolates were streaked 5 days prior to pathogen inoculation in 90 mm (Ø) Petri dishes and incubated at 32 ± 2 °C (Kunova et al. 2016). Separate control plates for each pathogen without the test isolate and 3 replications were maintained. Completely randomized block design (CRBD) was adopted to analyze the experiment results. The inhibition percentage of mycelial growth (PI) was calculated using the formula (Shrivastava et al. 2017),
Radial growth of the pathogens (mm), zone of inhibition (in mm) was measured and multiple comparisons were subjected to ANOVA.
Morphological characterization of melanogenic actinobacteria
Actinobacterial isolates were cultured on SCA to record macro and micro morphological characteristics after incubation at 32 °C for 7–10 days. Micro morphological characteristics like spore morphology and spore chain pattern, were studied using Environmental Scanning Electron Microscope (ESEM) (Model: Quanta 250, Czech Republic) (Sharma et al. 2014). For this study, actinobacterial spore mass was fixed on the stub followed by lyophilization and thin sputtering with gold (15 μ) using rotary vacuum pump. Tungsten was used as an electron source over the samples at appropriate rate and the emitted electrons from the sample were detected by large field detector (LFD) at high vacuum and converted to images.
Molecular characterization of melanogenic actinobacteria
The genomic DNA was extracted from spore masses of the actinobacterial isolates as described by Magarvey et al. (2004) with slight modifications. Polymerase Chain reaction (PCR) of 16S rRNA gene of the isolates was done with 27F (5′AGRGTTYGATYMTGGCTCAG3′) and 1492R (5′GGYTACCTTGTTACGACTT3′) universal primers (Byers et al. 1998). The temperature profile of PCR (1) 94 °C of initial denaturation for 5 min, (2) 35 cycles of denaturation at 94 °C for 1 min, primer annealing at 55 °C for 1 min, primer extension at 72 °C for 40 s and (3) 10 min at 72 °C of final extension. Amplified PCR product was sequenced and the sequences of Actinoalloteichus showing the highest scores from Genbank were selected for phylogenetic analysis. Multiple sequences were aligned by ClustalW algorithm and phylogenetic tree was constructed by adopting Neighbour-Joining (NJ) method with the MEGA software v.11.0. The genetic distances were computed using the Kimura-2-parameter method, bootstrap analysis was done with 1000 replications and adopted pairwise deletions for treating gaps (Mahadevakumar et al. 2017).
Extremophilic characterization of melanogenic actinobacteria
The halo, alkali, fungicide and UV-B tolerance level of the isolates M11 and M12 were studied along with control plates without stress factors. The growth of potent isolates on SCA in the presence of different concentrations of NaCl and Na2CO3were recorded (Rasuk et al. 2017). Petri dishes were visually evaluated after 10 days of incubation at 32 °C and categorized into: + positive/visible growth; ++ moderate; +++ excellent and − negative/no growth (Ayari et al. 2012). Likewise, the response of potent isolates to temperature range was studied at 0.5% NaCl and pH 7. Tolerance to the fungicide carbendazim from 10 to 1000 ppm was evaluated by poison food technique in SCA (NaCl 0.5% and pH 7) after 10 days of incubation at 32 °C (Arya and Sharma 2014). UV B resistance of melanogens was evaluated after exposing 7 days old cultures to artificial UV B light source for varied time durations at the distance of 10 cm (Rasuk et al. 2017).
Results
Isolation and identification of mulberry root rot pathogens
Root rot infected plants showed typical symptoms like dried, brown wilted foliage, soft rotten/decayed root systems, squashy barks releasing gummy exudates with foul smell/black sclerotial bodies and blocked xylem vessels. The pathogens viz., Macrophomina phaseolina, Lasiodiplodia theobromae, Fusarium solani, Sclerotium rolfsii and Rhizoctonia solani were isolated from diseased plants collected from different mulberry gardens. The isolated pathogens were identified according to morphological characteristics and confirmed using partial sequencing of ITS region.
Pathogenicity tests
In pathogenicity tests, the mycelia of Lasiodiplodia and Macrophomina spread vastly beneath the bark and emerged from both cortical ends (Fig. 1). Rotting progressed with blackening of bark and later pycnidial bodies/sporulations appeared through disintegrated root bark within 10 days after inoculation (DAI). However, the growth of Fusarium sp. was slow, thin as compared to the above pathogens yet with enormous sporodochia production and prominent color change in xylem vessels.
No visible mycelial growth was observed in case of R. solani, but root bits became soft and shrunken in size with browning of cortical tissues. Mycelium of S. rolfsii profusely spread over the epidermis and sclerotia production was seen within 20DAI. Un-inoculated control root bits remained healthy and re-isolation of the pathogens from disintegrated bits, resulted the respective pathogens, thus confirming pathogenicity (Fig. 1.).
Isolation and screening of melanogenic actinobacteria against root rot pathogens
Twelve melanogenic actinobacteria isolates were obtained during isolation from mulberry rhizosphere soil. Actinobacterial colonies appeared as small, powdery and the most of melanogenic isolates had dull/pale colored aerial mycelia rather than bright appearance. They observed to be less leathery on the agar surface producing smooth, friable colonies. The isolates M5, M6, M9, M10, M11 and M12 produced good amount of diffusible melanoid substances whereas mild black pigments observed around the colony of M1, M2, M3, M4, M7 and M8 isolates. Subsequently the potential anti-fungal strains had been identified by screening against fungal pathogens associated with mulberry root rot disease.
Among 12 isolates, M11 and M12 showed broad antifungal activity against 5 pathogenic fungi isolated from infected mulberry roots. However, M12 isolate exhibited significantly maximum antifungal action over M11 (Table 1, Fig. 2). Both the isolates recorded excellent inhibitory activity (IZ > 18 mm) towards all the pathogens except moderate activity by M11 against S. rolfsii (IZ-15 mm). The actinobacterial isolates (M11 and M12) exhibited more than 50 per cent reduction of mycelial growth of all the pathogens with respect to the control (Table 1). Highest PI was noticed against the pathogen R. solani (88.89%) followed by F. solani (84.44%) whereas least in S. rolfsii (57.78%)
In-vitro screening of melanogenic actinobacteria against mulberry root rot pathogens. a b M11 and M12 versus Macrophomina phaseolina, c, d M11 and M12 versus Lasiodiplodia theobromae, e, f M11 and M12 versus Fusarium solani, g, h M11 and M12 versus Rhizoctonia solani; i, j M11 and M12 versus Sclerotium rolfsii
Characterization of potential melanogenic isolates
Life cycle of A. cyanogriseus observed as initial colorless substrate mycelia before black diffusible pigment production followed by grayish aerial mycelia and sporulation in 5 days (Fig. 3a, c). There were slight differences observed among the isolates M11 and M12 (Table 2). They were aerobic, gram positive with cell wall type III. The entire agar turned into black due to extracellular diffusible melanoid pigment synthesis and distribution. Even black dew/watery droplets were found on M12 colonies after two weeks of incubation.
Cells were gram-positive and cocci shaped under 400x. ESEM observations revealed that the isolates M11 and M12 had more than 10 spores per chain. The spore size of M12 isolate was notably smaller than M11, however, both the isolates had smooth surfaced spores and arranged in rectiflexible chains (Fig. 3b, d).
Sequence analysis indicated that the strains M11 and M12 were affiliated to the genus Actinoalloteichus and had the highest similarity with A. cyanogriseus DSM 40103 (100%) followed by A. spitiensis (99.53%), A. hymeniacidonis DSM 45092 (99%), A. hoggarensis DSM 45943 (99%), A. fjordicus ADI127-7 (99%). The 16S rRNA gene sequence of the potent isolates M11 (1454 bp) and M12 (1363 bp) were deposited at NCBI GenBank under accession numbers OK447751 and OL657042 respectively (Fig. 4). The neighbor joining (NJ) phylogenetic tree was constructed with the MEGA software v.11.0 with 16 other related sequences (Fig. 4). The tree depicted that the isolates of current study formed a distinct lineage within the genus Actinoalloteichus highlighted in red and supported with good bootstrap values.
Neighbor joining (NJ) phylogenetic tree constructed from 16S r RNA sequences of potent isolates along with other 16 sequences belonging to the genera Actinoalloteichus. The sequences were aligned using ClustalW algorithm and adopted pairwise deletion for gaps. The confidence limits estimated from a bootstrap analysis with 1000 replications
Both the isolates were mesophilic and growth of A. cyanogriseus was recorded at temperature range of 27 to 40 °C and optimum at 32 °C (Table 3). Diffusible black pigment was produced early at optimum temperature on SCA, slow or poor sporulation and melanin production was observed at temperature (< 20 °C and > 40 °C). Both isolates did grow well under broad pH conditions (7–9) and however, only M11 tolerated NaCl concentration of 7.5-%. In poison food technique, the isolates showed normal growth up to 500 ppm of carbendazim. Very slow growth and late/poor melanin production were observed at 1000 ppm concentration. Both M11 and M12 isolates showed tolerance to UV B rays up to the tested duration of 180 min. The isolates also exhibited normal growth as like control and early pigmentation when compared to other abiotic stresses including alkalinity, salinity and NaCl.
Discussion
Symptoms of root rot affected mulberry plants were similar as observed by previous studies (Govindaiah et al. 2005). Riaz et al. (2007) recorded progressive wilting, premature drying, loss of vigor and yield reduction as the characteristic root rot symptoms in mulberry plants. In addition to the pathogens isolated in this study, like, Rhizopus oryzae, Helicobasidium mompa, Rosellinia necatrix, Armilaria mellea were also associated with the mulberry root rot disease (Gnanesh et al. 2020). However, they cause root rot in mulberry either as a single/primary pathogen or otherwise as complex interaction of two or more pathogens. Pathogenicity tests on sterilized mulberry root bits assisted in visualizing the development and infection process of root rot casual agents. Open wounds ensures and enhances infection process. Yoshida et al. (2001) mentioned detached root cortex method as more suitable for preliminary quick screening. Rotting intensity including softening of root tissue followed by discolorations and disintegration was noticed with age, however virulent isolates exhibited early infection symptoms. Previously, (Gnanesh et al. 2020) observed rotting of cortical tissues in root segments around Rhizopus mycelia block similar to that of natural infection in mulberry.
Pre-treatment of samples reduced the gram negative bacterial population in the soil samples (Saadoun et al.1999) which eased isolation procedure. Mulberry rhizosphere soil was focused in this study to isolate novel and endemic antagonist as well. Antimicrobial properties of root exduates were also increasing the chances of rare and potent actinobacterial isolation (Ashokvardhan et al. 2014). Soil heat treatment assisted in early sporulation of actinobacteria and enhanced isolation of melanogenic actinobacteria. Though melanin is not important for growth and development, it effectively protects actinobacteria from extreme temperature and UV rays (Amal et al. 2011) which added advantage over other biocontrol agents.
Mohamed et al. (2017) categorized degree of antimicrobial activity of actinobacteria isolated from extreme ecosystem based on the diameter of inhibition zone (IZ) in dual culture assay. Accordingly, M12 isolate showed excellent antifungal activity (IZ > 18 mm) towards all pathogens and the highest inhibition was recorded against F. solani (IZ-37 mm). Similar studies were observed strong inhibitory activity of Streptomyces K20 (IZ-27 mm) against M. phaseolina (Shrivastava et al. 2017) isolated from saline soil. Earlier reports showed that the inhibitory zone formation was directly related to the antimicrobial metabolites produced by antagonists (Franks et al. 2006). In the life of cycle of actinobacteria, bioactive metabolites production was coordinated with sporulation and it was increased during stress condition (Kunova et al. 2016). The results corroborated with previous reports and consequently, antibiosis effect increased during sporulation. In antibiosis, antimicrobial metabolites had direct impact on metabolism of pathogens even at very low concentrations (Ons et al. 2020). Zhang et al. (2021) reported that metabolites of A. cyanogriseus 12A22 showed antifungal activity against F. oxysporum f. sp. cucumerinum (IZ-10 mm) and R. solani (IZ-8 mm) at the concentration of 1mg/ml (0.1%).
Kunova et al. (2016) studied antifungal interaction of Streptomyces sp. against 6 soil-borne fungal pathogens and results showed maximum inhibitory action of 72% and 47% against R. solani and F. oxysporum, respectively. Zou et al. (2021) also recorded maximum PI of 79.9% against F. oxysporum by Streptomyces sp. There were several reports available on antibacterial efficacy of melanogenic actinobacteria (Prajapati et al. 2016), whereas antifungal potency of melanogenic isolates is unexplored/poorly studied.
The screened potential isolates were characterized, compared to those of the known actinobacteria and identified as Actinoalloteichus cyanogriseus at genetic level. Morphological characters were similar to the genus as described earlier (Zhang et al. 2021). Melanin production or melanogenesis was reported in various actinobacterial members. This metabolic polymer neutralized free radicals, showed anti-bacterial activity, tolerance to high temperature, UV and chemicals (El-Naggar and El-Ewasy 2017). Further they have been reported as ‘armour’ as improving survival and competitiveness of the organism. Other than A. cyanogriseus, A. hymeniacidonis and A. nanshanensis were also identified as black pigment producing members in this genus (Schaffert et al. 2016). Spore characteristics are important in the taxonomy of actinobacteria and the genus Actinoalloteichus produced straight spore chains from aerial mycelia (Xiang et al. 2011). Zhang et al. (2021) also recorded the spore of A. cyanogriseus as smooth surfaced of size 0.7–0.5 1.1–0.8 μm and arranged in straight or rectiflexible chains.
The rare genus Actinoalloteichus was named based on the difference in cell wall composition and described as new taxa for the first time by Liu et al. (1984). Until now, 6 species belonging to this genus were identified including A. cyanogriseus, A. spitiensis, A. hymeniacidonis, A. nanshanensis, A. hoggarensis and A. fjordicus, from soil, desert and marine environments (Zhang et al. 2021). However, A. caeruleus and S. caeruleus had been identified as synonym of A. cyanogriseus (Tamura et al. 2008). They were multifarious and produced variety of secondary metabolites due to its origin from unique environment. Besides, A. cyanogriseus belonged to the family Pesudonocardiaceae, presently comprising 32 genera and with closest neighbors from the genera, Kutzneria and Streptoalloteichus (Stackebrandt et al. 1997). However, they were distinguished from other genera within the family by chaemotaxonomic properties and non-motile cells/sporangia production (Tamura et al. 2000).
Tamura et al. (2000) also reported that A. cyanogriseus as mesophilic, grew between 20 and 37 °C and showed NaCl tolerance up to 7%. Extremophiles are not limited to extreme environments and the potent isolates of present study were the evidence followed by Bacillus thermoalcaliphilus (Sarkar 1991). These isolates were obtained from healthy mulberry rhizosphere, though exhibited moderate tolerance to temperature, NaCl and salinity. Methyl-1H-benzimidazol-2-ylcarbamate (MBC) is a systemic benzimidazole fungicide either used as foliar spray or directly in the soil against fungal diseases like powdery mildew, root rot, blight, etc. in mulberry. Integrated disease management (IDM) was widely followed to attain maximum inhibition of pathogen in fields. Combination of bio-agents with chemical fungicides have been followed to reduce fungicidal concentrations and to avoid development of fungicide resistance in pathogens (Ons et al. 2020). Apart from survivability, Arya and Sharma (2014) also mentioned S. albogriseolus as a persuasive MBC bio-remediation agent. Hence, these isolates could be applied in combination with fungicide for maximum disease control and to nullify the negative/residual effects of MBC on soil, mulberry and silkworm as well. The melanoid pigments production in microbes had already reported as UV tolerant ability (Amal et al. 2011). Moreover, among extremophilies, UV resistant actinobacteria had high potential for the discovery of novel natural products (Rasuk et al. 2017).
Identification of potent, stable and broad spectrum antifungal bioagents necessitate for the management of soil-borne phytopathogens in mulberry. Their compatibility with the fungicides and cultural practices which adopted in crop cultivation added advantage to develop effective IDM strategies.
Conclusions
It was concluded that two novel melanogenic actinobacterial isolates possessing multifaceted antifungal activity were obtained from the healthy mulberry rhizosphere in a severely root rot infested garden. Thus, the stressed/diseased environments could be considered as a prolific resource for identifying a potent micro-organism. Phenotyphic, genomic and phylogenetic analyses revealed the isolates localized in the clade of the rare genus, Actinoalloteichus and had the highest similarity with A. cyanogriseus. These isolates showed excellent inhibitory action towards the phytopathogens viz., M. phaseolina, L. theobromae, F. solani, S. rolfsii and R. solani. Their antagonism was found to be multifarious including, production of melanoid substances, diffusible bioactive metabolites, competitiveness and multi-stress tolerant ability.
Also, extremophilic characteristics of the melanogenic isolates, further made it potential candidate that could be incorporated in eco-friendly, integrated disease management strategies and hence merit future studies.
Availability of data and materials
Not applicable.
Abbreviations
- PDA:
-
Potato dextrose agar
- ITS:
-
Internal transcribed spacer region
- CTAB:
-
Cetyltrimethyl ammonium bromide
- SCA:
-
Starch casein agar
- CRBD:
-
Completely randomized block design
- PI:
-
Per cent inhibition over control
- IZ:
-
Inhibition zone
- RG:
-
Radial growth of pathogen
- ESEM:
-
Environmental Scanning Electron Microscope
- LFD:
-
Large field detector
- PCR:
-
Polymerase chain reaction
- NJ:
-
Neighbour-Joining method
- DAI:
-
Days after inoculation
- MBC:
-
Methyl-1H-benzimidazol-2-ylcarbamate
- IDM:
-
Integrated disease management
References
Abdallah ME, Haroun SA, Gomah A, El-Naggar NE, Badrc HH (2013) Application of actinomycetes as biocontrol agents in the management of onion bacterial rot diseases. Arch Phytopathol Pflanzenschutz 46(15):1797–1808
Amal AM, Abeer KA, Samia HM, Nadia AENH, Ahmed KA, El-Hennawi HM (2011) Selection of Pigment (Melanin) production in Streptomyces and their application in printing and dyeing of wool fabrics. Res J Chem Sci 1(5):22–28
Arya R, Sharma AK (2014) Bioremediation of carbendazim by Streptomyces albogriseolus. Biointerface Res Appl Chem 4(4):804–807
Ashokvardhan T, Rajithasri AB, Prathyusha P, Satyaprasad K (2014) Actinomycetes from Capsicum annuum L. rhizosphere soil have the biocontrol potential against pathogenic fungi. Int J Curr Microbiol Appl Sci 3(4):894–903
Ayari A, Morakchi H, Kirane Gacemi D (2012) Identification and antifungal activity of Streptomyces sp. S72 isolated from Lake Oubeira sediments in North-East of Algeria. Afr J Biotechnol 11:305–311
Byers HK, Stackebrandt E, Hayward C, Blackall LL (1998) Molecular investigation of a microbial mat associated with the great artesian basin. FEMS Microbiol Ecol 25:391–403
Choudhari SS, Solanke NS, Kareppa BM (2012) Integrated management of root rot disease of mulberry caused by Fusarium solani. Multilogic Sci 2(2):135–139
Chowdary NB, Reddy MM (2004) Influence of edaphic and abiotic factors responsible for outbreak of root rot disease. Annual report, Central Sericultural Research and Training Instutute, Mysore, India, pp 42–43
Chowdary NB, Govindaiah (2009) Leaf yield loss assessment due to Macrophomina root rot disease in mulberry gardens of south India. Arch Phytopathol Pflanzenschutz 42(11):1055–1058. https://doi.org/10.1080/03235400701621826
Conn VM, Walker AR, Franco CM (2008) Endophytic actinobacteria induce defense pathways in Arabidopsis thaliana. Mol Plant Microbe Interact 21(2):208–218. https://doi.org/10.1094/MPMI-21-2-0208
El-Naggar NE, El-Ewasy SM (2017) Bioproduction, characterization, anticancer and antioxidant activities of extracellular melanin pigment produced by newly isolated microbial cell factories Streptomyces glaucescens NEAE-H. Sci Rep 14:42129. https://doi.org/10.1038/srep42129
Franks A, Egan S, HolmstrOm C, James S, Lappin-Scott H, Kjelleberg S (2006) Inhibition of fungal colonization by Pseudoalteromonas tunicata provides a competitive advantage during surface colonization. Appl Environ Microbiol 72:6079–6087
Gnanesh BN, Tejaswi A, Arunakumar GS, Supriya M, Manojkumar HB, Tewary P (2020) Molecular phylogeny, identification and pathogenicity of Rhizopus oryzae associated with root rot of mulberry in India. J Appl Microbiol 131(1):360–374. https://doi.org/10.1111/jam.14959
Gottlieb D (1973) General consideration and implications of the actinomycetales. In: Sykes G, Skinner FA (eds) Actinomycetales characteristics and practical importance. Academic Press, pp 1–10
Govindaiah G, Gupta VP, Sharma DD, Rajadurai S, Naik NV (2005) Mulberry crop protection. Central Silk Board, pp 207–215
He YQ (2000) An improved protocol for fungal DNA preparation. Mycosystema 19:434
Jimenez-Diaz RM, Castillo P, del Mar J-G, Landa BB, Navas-Cortés JA (2015) Fusarium wilt of chickpeas: biology, ecology and management. Crop Prot 73:16–27
Khanna KM, Renu S, Rup L (2011) Selective isolation of rare actinomycetes producing novel antimicrobial compounds. Int J Adv Biotechnol Res 2:357–375
Kunova A, Bonaldi M, Saracchi M, Pizzatti C, Chen X, Cortesi P (2016) Selection of Streptomyces against soil borne fungal pathogens by a standardized dual culture assay and evaluation of their effects on seed germination and plant growth. BMC Microbiol 16(1):272
Liu Z, Zhang Y, Yan X (1984) A new genus of the order Actinomycetales. Acta Microbiol Sin 24:295–298
Magarvey NA, Keller JM, Bernan V, Dworkin M, Sherman DH (2004) Isolation and characterization of novel marine-derived actinomycete taxa rich in bioactive metabolites. Appl Environ Microbiol 70(12):7520–7529. https://doi.org/10.1128/AEM.70.12.7520-7529.2004
Mahadevakumar S, Amruthavalli C, Sridhar KR, Janardhana GR (2017) Prevalence, incidence and molecular characterization of Phomopsis vexans causing leaf blight and fruit rot disease of brinjal in Karnataka (India). Plant Pathol Quar 7(1):41–58. https://doi.org/10.5943/ppq/7/1/5
Mihail JD (1992) Macrophomina. In: Singleton LL, Mihail JD, Rush CM (eds) Methods for research on soil-borne phytopathogenic Fungi. APS Press, p 134
Mohamed H, Miloud B, Zohra F, García-Arenzana JM, Veloso A, Rodríguez-Couto S (2017) Isolation and characterization of Actinobacteria from Algerian Sahara soils with antimicrobial activities. Int J Mol Cell Med 6:109–120
Mukunda K, Teligi V, Puttegowda SH, Sampangiramaiah KD (2021) Disease incidence, severity and phenotypic variation among the isolates of Rhizoctonia bataticola infected in root rot disease of mulberry in different mulberry fields of Karnataka. Biosci Biotech Res Asia 18(2):403–411
Ons L, Bylemans D, Thevissen K, Cammue B (2020) Combining biocontrol agents with chemical fungicides for integrated plant fungal disease control. Microorganisms 8(12):19–30. https://doi.org/10.3390/microorganisms8121930
Oskay AM, Usame T, Cem A (2004) Antibacterial activity of some actinomycetes isolated from farming soils of Turkey. Afr J Biotechnol 3(9):441–446
Pappachan A, Rahul K, Irene L, Sivaprasad V (2020) Molecular identification of fungi associated with mulberry root rot disease in Eastern and North Eastern India. J Crop Weed 16:180–185. https://doi.org/10.22271/09746315.2020.v16.i1.1291
Prajapati H, Modi S, Poonam BC, Gahlout M (2016) Extraction and isolation of melanin from actinomycetes. Int J Drug Res Tech 6(2):79–86
Ramesh H, Sivaram V, Murthy VY (2014) Antioxidant and medicinal properties of mulberry (Morus sp.): a review. World J Pharm Res 3(6):320–343
Rasuk M, Ferrer G, Kurth D, Portero L, Farias M, Albarracin V (2017) UV-resistant actinobacteria from high-altitude Andean Lakes: isolation, characterization and antagonistic activities. Photochem Photobiol 93:865–880. https://doi.org/10.1111/php.12759
Riaz A, Khan SH, Iqbal SM, Shoaib M (2007) Pathogenic variability among Macrophomina phaseolina (Tassi) Goid, isolates and identification of sources of resistance in mash against charcoal rot. Pak J Phytopathol 19(1):44–46
Saadoun I, Hameed K, Moussauui A (1999) Characterization and analysis of antibiotic activity of some aquatic actinomycetes. Microbios 99(394):173–179
Sarkar A (1991) Isolation and characterization of thermophilic, alkaliphilic, cellulose degrading Bacillus thermoalcaliphilus sp. nov. from termite (Odontotermes obesus) mound soil of a semiarid area. Geomicrobiol J 9:225–232
Schaffert L, Albersmeier A, Winkler A, Kalinowski J, Zotchev SB, Ruckert C (2016) Complete genome sequence of the actinomycete Actinoalloteichus hymeniacidonis type strain HPA 177T isolated from a marine sponge. Stand Genom Sci 11:91. https://doi.org/10.1186/s40793-016-0213-3
Sharma M, Dangi P, Choudhary M (2014) Actinomycetes: source, identification, and their applications. Int J Curr Microbiol Appl Sci 3(2):801–832
Shrivastava P, Kumar R (2015) Soil salinity: a serious environmental issue and plant growth promoting bacteria as one of the tools for its alleviation. Saudi J Biol Sci 22(2):123–131. https://doi.org/10.1016/j.sjbs.2014.12.001
Shrivastava P, Kumar R, Yandigeri MS (2017) In vitro biocontrol activity of halotolerant Streptomyces aureofaciens K20: a potent antagonist against Macrophomina phaseolina (Tassi) Goid. Saudi J Biol Sci 24(1):192–199. https://doi.org/10.1016/j.sjbs.2015.12.004
Stackebrandt E, Rainey FA, Ward-Rainey NL (1997) Proposal for a new hierarchic classification system, Actinobacteria classis nov. Int J Syst Bacteriol 47:479–491
Tamura T, Zhiheng L, Yamei Z, Hanato K (2000) Actinoalloteichus cyanogriseus gen. nov., sp. nov. Int J Syst Evol Microbiol 50:1035–1040
Tamura T, Ishida Y, Otoguro M, Hatano K, Labeda D, Price NP, Suzuki K (2008) Reclassification of Streptomyces caeruleus as a synonym of Actinoalloteichus cyanogriseus and reclassification of Streptomyces spheroides and Streptomyces laceyi as later synonyms of Streptomyces niveus. Int J Syst Evol Microbiol 58:2812–2814
Xiang W, Liu C, Wang X, Du J, Xi L, Huang Y (2011) Actinoalloteichus nanshanensis sp. nov., isolated from the rhizosphere of a fig tree (Ficus religiosa). Int J Syst Evol Microbiol 61:1165–1169. https://doi.org/10.1099/ijs.0.023283-0
Yoshida S, Murakami R, Watanabe T, Koyama A (2001) Rhizopus rot of mulberry-grafted saplings caused by Rhizopus oryzae. J Gen Plant Pathol 67:291–293
Zhang X, Song C, Bai Y, Hu J, Pan H (2021) Cytotoxic and antimicrobial activities of secondary metabolites isolated from the deep-sea-derived Actinoalloteichus cyanogriseus 12A22. 3 Biotech 11(6):283. https://doi.org/10.1007/s13205-021-02846-0
Zou N, Zhou D, Chen Y, Lin P, Chen Y, Wang W, Xie J, Wang M (2021) A novel antifungal actinomycete Streptomyces sp. strain H3–2 effectively controls banana Fusarium Wilt. Front Microbiol 12:22–26. https://doi.org/10.3389/fmicb.2021.706647
Acknowledgements
Authors gratefully acknowledge the Department of Sericulture, Department of Plant Pathology, Tamil Nadu Agricultural University Coimbatore for extending necessary facilities to carry out the experiments.
Funding
Corresponding author would like to record acknowledgement for the financial assistance from University Grants Commission, New Delhi, for doctoral research program.
Author information
Authors and Affiliations
Contributions
This work was carried out in collaboration among all authors. MS and KA designed the study. MS performed the laboratory experiments and produced the manuscript. KA and SK revised the manuscript. SM and KC managed the literature searches. All authors read and approved the final manuscript.
Corresponding author
Ethics declarations
Ethics approval and consent to participate
Not applicable.
Consent for publication
Not applicable.
Competing interests
All the authors declared that they have no competing interests.
Additional information
Publisher's Note
Springer Nature remains neutral with regard to jurisdictional claims in published maps and institutional affiliations.
Rights and permissions
Open Access This article is licensed under a Creative Commons Attribution 4.0 International License, which permits use, sharing, adaptation, distribution and reproduction in any medium or format, as long as you give appropriate credit to the original author(s) and the source, provide a link to the Creative Commons licence, and indicate if changes were made. The images or other third party material in this article are included in the article's Creative Commons licence, unless indicated otherwise in a credit line to the material. If material is not included in the article's Creative Commons licence and your intended use is not permitted by statutory regulation or exceeds the permitted use, you will need to obtain permission directly from the copyright holder. To view a copy of this licence, visit http://creativecommons.org/licenses/by/4.0/.
About this article
Cite this article
Saratha, M., Angappan, K., Karthikeyan, S. et al. Actinoalloteichus cyanogriseus: a broad spectrum bio-agent against mulberry root rot pathogens. Egypt J Biol Pest Control 32, 33 (2022). https://doi.org/10.1186/s41938-022-00532-8
Received:
Accepted:
Published:
DOI: https://doi.org/10.1186/s41938-022-00532-8